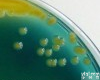
<em>无花果</em><em>曲霉</em>规格

无花果曲霉Aspergillus ficuum 编号SHBCC D15802
- 品牌:上海保藏生物技术中心SHBCC
- 型号:SHBCC D15802
- 产地:上海
- 供应商:上海瑞楚生物科技有限公司
- 供应商报价:¥1000
- 标签:无花果曲霉Aspergillus ficuum 编号SHBCC D15802、无花果曲霉Aspergillus ficuum 编号SHBCC D15802价格、无花果曲霉Aspergillus ficuum 编号SHBCC D15802厂家、Aspergillus ficuum、、上海瑞楚生物科技有限公司